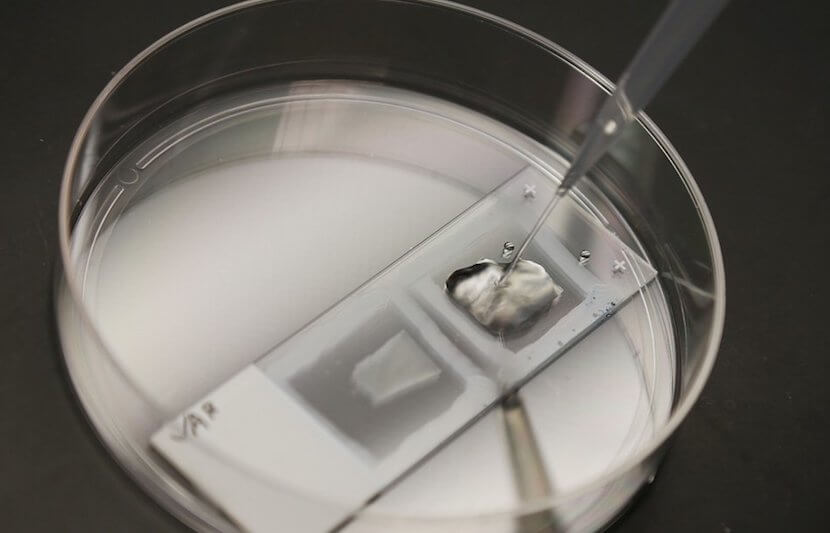
MIT and Harvard Medical School’s New Microscopy Technique Could Help Spot Cancer and Other Diseases Earlier and More Accurately Than Current Diagnostic Tools

-
Simon Fraser University Student Decodes Honeybee Health From Bee Buzz
Ever wonder what honeybees are saying to each other as they buzz busily around their hive? You won’t have to wonder for long. Oldooz Pooynfar, a graduate student at Simon Fraser University (SFU) in British Columbia, Canada, has devised a new technology that aims to find out exactly what the honeybees are communicating to each… Read More
-
Trinity College Dublin Scientists Make Significant Breakthrough for Allergic Conditions
Researchers at Trinity College in Dublin, Ireland have made a significant breakthrough in the treatment of allergic conditions, such as asthma and eczema. The team, led by Science Foundation Ireland Stokes Professor of Translational Immunology, Padraic Fallon, of the School of Medicine in the Trinity Biomedical Sciences Institute, demonstrated that a molecule, referred to as… Read More
-
Dartmouth College Student Introduces Campus Green2Go Food Takeout Program to Help Sustainability
Takeout meals are becoming increasingly popular and more common in college campuses where students rush from one class to the next with just minutes to eat in between. Even when their long days are over, many students find themselves eating in their dorms or on their campus quads. At Dartmouth College, Madison Sabol, a rising… Read More
-
Ohio State University Researchers Develop Technology That Could Help Reprogram Cells to Repair and Regenerate as Needed
A team of researchers at the Ohio State University (OSU) Wexner Medical Center and OSU’s College of Engineering has developed Tissue Nanotransfection (TNT), a new technology capable of generating cells needed to repair and restore tissue in patient’s organs, blood vessels, and nerve cells. The study was recently published in the journal Nature Nanotechnology. The… Read More
-
University at Buffalo Researchers Develop New Optical Device That Could Detect Drugs or Explosives
A team of researchers led by engineers from University at Buffalo in New York (UB) has developed an optical device that has the potential to vastly increase the sensitivity and effectiveness of current drug and explosive detection techniques. The University Network (TUN) spoke with Qiaoqiang Gan, associate professor of electrical engineering in the School of… Read More
-
Harvard and Boston University’s New Robotic Exosuit Helps Stroke Victims Walk Normally
A research team at Harvard University’s John A. Paulson School of Engineering and Applied Sciences (SEAS), in conjunction with the Wyss Institute for Biologically Inspired Engineering at Harvard and Boston University’s College of Health & Rehabilitation Sciences: Sargent College, have developed a prototype “exosuit” to help stroke victims walk normally. A stroke can have an… Read More
-
Stanford and UC San Diego Researchers Develop 4D Camera That Could Enhance Robotic Vision and Augmented and Virtual Reality
A team of researchers from Stanford University and University of California, San Diego have developed a brand new kind of camera with robotics in mind. This new camera will remove a key challenge robotics engineers face today in terms of capturing images. Digital cameras, even the top-of-the-line models, are not well-suited for capturing the wide… Read More
-
University of Surrey Researchers Move the Needle Closer Towards Quantum Computing With Their ‘Dancing’ Phosphorus Atoms
Quantum computing has taken a great leap forward thanks to a team of University of Surrey researchers led by Dr. Steve Chick and Professor Ben Murdin. They have successfully manipulated phosphorus atoms within silicon crystals (the material existing digital computer circuits are made of) and made them “dance” by controlling their shape and size. The… Read More
-
CarCMU Researchers Develop Method to Remove 99% of Harmful Chemical Contaminant BPA From Water
A team of researchers from Carnegie Mellon University (CMU) has successfully developed a solution to remove one of the most prominent industrial chemical contaminants, bisphenol A (BPA), from our water. In their study, the researchers were able to remove 99 percent of BPA from water using a mixture of hydrogen peroxide and engineered catalysts. The… Read More
-
The Moon’s Interior May Actually Be Rich in Water, According to Brown University Researchers
Scientists at Brown University have used satellite data to discover water within ancient explosive volcanic deposits on the Moon, indicating that its interior contains substantial amounts of indigenous water. They found that volcanic deposits distributed across the surface of the Moon contained a surprisingly large amount of trapped water in comparison with surrounding terrains. The… Read More
-
University of Washington School of Medicine Researchers’ Success in Regenerating Retinal Cells in Mice Has Potential to Restore Human Sight
A team of researchers at the University of Washington School of Medicine in Seattle has found a way to successfully regenerate cells in the retina of adult mice. These results could eventually lead to the treatment of damage caused by injury to the retina, including trauma, glaucoma, and other eye diseases. The research is published… Read More
-
University of Virginia Public Benefit Company Makes Splash with Water Purification Technology
There has never been better a better time for advances in the area of water purification. As the crisis involving safe and drinkable water throughout many third world countries continues to prove problematic, many countries across the developed world are working to create innovative and new ways of solving this problem in as sustainable a… Read More
-
University of Sydney Researchers Building Superfast Blockchain Technology That Could Revolutionize Cryptocurrency Transactions
Researchers from the University of Sydney’s School of Information Technologies are developing a superfast blockchain technology that they believe has the potential to make bitcoin-based transactions possible around the world. A blockchain is a virtual public ledger that processes and records transactions. Blockchain is the underlying technology for bitcoin, the cryptocurrency, but bitcoin hasn’t taken… Read More
-
Rhode Island College Uses Solar and Wind Power for Outdoor Lighting and Springboard for New Course
Recent steps taken by Rhode Island College (RIC) confirm its commitment to sustainability. In addition to converting all its dormitories to LED lighting, which will save 517,308 kilowatt hours, RIC has installed several street lamps topped with solar panels and a wind turbine. During the day, the lamps convert sunlight and wind into electricity, which… Read More
-
MIT and Harvard Medical School’s New Microscopy Technique Could Help Spot Cancer and Other Diseases Earlier and More Accurately Than Current Diagnostic Tools
Up until now, microscopy (magnifying a set image or object) has been limited. Conventional light microscopes that use an eyepiece lens to magnify what is being observed through the objective lens do not reveal “fine-scale details” of cells. Although there are high-resolution electron microscopes capable of enlarging the image of tissues, molecules, and other features… Read More